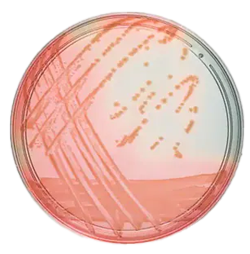

Useful Links
Save Now - Exclusive Deals
Product Code 10473673
Product Code 4523608
Product Code 11934042
Product Code 13245359
Product Code 12942638
Product Code 13265339
Product Code 11974102
Product Code 11632139
Product Code 11790896
Product Code 10612592
Product Code 15972710
Product Code 11994172
Must Have
Product Code 7113093
Product Code 7000009
Product Code 10240973
Product Code 11974132
Product Code 12769090
Product Code 4231973
Product Code 10544951
Complete Your Order - Great Deals
Product Code 4842411
Product Code 8000185
Product Code 4530188
FAQ
Selecting the appropriate prepared microbiology media depends on several factors related to the specific needs of your experiment or application. Here are key considerations to guide your selection:
Type of Microorganism:
- Bacteria: Nutrient agar, tryptic soy agar, or blood agar for general bacterial growth
- Fungi: Sabouraud dextrose agar or potato dextrose agar
- Specific Pathogens: Specialized media like MacConkey agar for Gram-negative bacteria or Mannitol salt agar for Staphylococci
Purpose of the Experiment:
- Isolation and Pure Culture: Use solid media like nutrient agar or blood agar to isolate colonies
- Enrichment: Use liquid media like nutrient broth to increase the number of microorganisms
- Differentiation: Use differential media like MacConkey agar to distinguish between different microorganisms based on color changes or other reactions
- Selective Growth: Use selective media that inhibit unwanted microorganisms while allowing the target organisms to grow. For example, Eosin Methylene Blue (EMB) agar for Gram-negative bacteria
Nutritional Requirements:
- General Nutrient Requirements: Use nutrient-rich media like tryptic soy agar or broth
- Fastidious Organisms: Use enriched media like blood agar or chocolate agar that provide additional nutrients
Physiological and Biochemical Tests:
- Carbohydrate Fermentation: Use media like phenol red broth with specific carbohydrates
- Motility Testing: Use semi-solid media like motility agar
- Enzyme Activity: Use media like starch agar to test for amylase activity or casein agar for protease activity
Environmental Conditions:
- Aerobic vs. Anaerobic: Ensure the media and incubation conditions match the oxygen requirements of the microorganisms
Regulatory and Standard Protocols:
- Clinical and Diagnostic Labs: Follow standardized media requirements set by regulatory bodies like CLSI (Clinical and Laboratory Standards Institute)
The terms "Petri dish" and "agar plate" are often used interchangeably, but they refer to different aspects of microbiological culture tools:
Petri Dish:
A Petri dish is a shallow, cylindrical, lidded dish made of glass or plastic. It is a container used to hold culture media and grow microorganisms. The dish itself does not contain any media or nutrients when it is empty.
Agar Plate:
An agar plate is a Petri dish that has been filled with a nutrient-rich agar medium. Agar is a gelatinous substance derived from seaweed, used to solidify the nutrient media. The agar plate serves as a growth medium where microorganisms can be cultured and observed.
Prepared microbiology media come in various forms, each designed for specific purposes. Here are examples of different types:
General Purpose Media:
- Nutrient Agar (NA): Used for the general cultivation of a wide variety of non-fastidious microorganisms
- Tryptic Soy Agar (TSA): Another general-purpose medium suitable for the growth of a broad range of microorganisms
Selective Media:
- MacConkey Agar: Selective for Gram-negative bacteria and differentiates lactose fermenters from non-fermenters
- Mannitol Salt Agar (MSA): Selective for Staphylococci due to its high salt concentration and differentiates based on mannitol fermentation
Differential Media:
- Blood Agar: Used to differentiate bacteria based on their hemolytic properties (e.g., alpha, beta, and gamma hemolysis)
- Eosin Methylene Blue (EMB) Agar: Differentiates between lactose fermenters, which produce dark colonies, and non-fermenters, which produce colorless colonies
Enriched Media:
- Chocolate Agar: Enriched with lysed red blood cells, used for growing fastidious organisms like Haemophilus influenzae and Neisseria species
- Blood Agar: Enriched with whole blood to support the growth of fastidious bacteria and to observe hemolytic activity
Enrichment Media:
- Selenite F Broth: Used to enrich Salmonella species from fecal and other samples
- Tetrathionate Broth: Enrichment medium for the isolation of Salmonella and Shigella species
Transport Media:
- Amies Medium: Used for the transport of clinical specimens, maintaining the viability of pathogens without promoting their growth